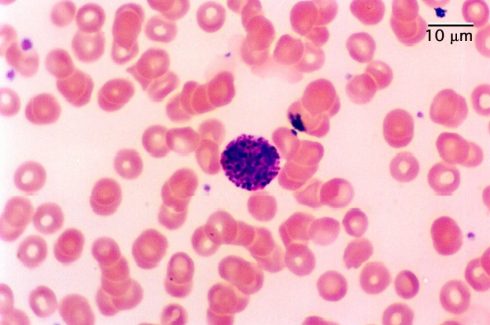
رنگ های رومانوفسکی: رنگ رایت گیمسا

رنگ های رومانوفسکی چیست؟
رنگ های رومانوفسکی رنگ هایی هستند که در مطالعات هماتولوژی و سیتولوژی جهت متمایز نمودن سلولها در بررسیهای میکروسکوپی نمونههای خون و مغز استخوان استفاده میشوند. این رنگ ها همچنین برای تشخیص وجود انگلهایی در خون مانند انگلهای مالاریا استفاده میشوند. انواع مختلفی از رنگ های رومانوفسکی وجود دارند که از رنگهای مبنای یکسانی استفاده میکنند که عبارتند از:
- رنگ Giemsa
- رنگ های Wright و Wright-Giemsa
- رنگ May-Grunwald
- رنگ Leishman
مجموعه این رنگ ها پس از این که Dmitri Leonidovich رومانوفسکی، پزشک روسی که برای اولین بار اهمیت استفاده از روشهای رنگآمیزی در نمونههای خون برای ایجاد و شناسایی اثرات را نشان داد، ابداع شد.

رنگ آمیزی خون با رنگ Giemsa: گلبول های سفید خون (در مرکز عکس) که توسط گلبول های قرمز احاطه شده اند.

تصویر خون رنگ آمیزی شده با Giemsa که Plasmodium را (در مرکز تصویر) نشان میدهد (انگلی که باعث عفونت مالاریا میشود).
اصول رنگ های رومانوفسکی
- رنگ های رومانوفسکی خنثی هستند و از رنگهای oxidized methylene blue (azure) و Eosin Y ساخته شدهاند.
- azureها رنگ های پایهای هستند که به هسته اسید متصل میشوند و رنگ آبی مایل به بنفش را تولید میکنند.
- رنگ اسیدی Eosin به سیتوپلاسم alkaline متصل میشود و رنگ قرمز ایجاد میکند.
- رنگ های رومانوفسکی عمدتاً بر روی توانایی خود در تولید انواع رنگها کار میکند که امکان تمایز اجزای مختلف سلولی را ممکن میسازد. این توانایی به عنوان اثر رومانوفسکی شناخته میشود که تحت عنوان Metachromasia نیز شناخته میشود.
- ترکیب Eosin Y و متیلن بلو (Methylene blue) فعال به رنگ هایی نسبت داده میشود که اجزای سلول را متمایز میکنند، که در آن سایههای ارغوانی در کروماتینهای (Chromatin) سلولی هسته و گرانولها (Granule) در سیتوپلاسم برخی از گلبولهای سفید شکل میگیرد و رومانوفسکی آن را به عنوان اثر رومانوفسکی یا اثر Romanowky-Giemsa تعریف کرد.
- علاوه بر این، رنگ های رومانوفسکی را میتوان با oxidized unmethylated methylene blue، به وسیله اثر oxidative demethylation ساخت. این امر منجر به تجزیه متیلن بلو به رنگهای Multichromatic میشود که برخی از آنها موجب اثر رومانوفسکی میشوند.
- متیلن بلو که تحت تاثیر oxidative demethylation قرار گرفته است به نام polychrome methylene blue شناخته میشود که دارای حدود 11 رنگ شامل azure A، azure B، azure C، متیلن بلو، methylene violet Bernthesen، methyl thionoline و thionoline میباشد.
انواع رنگ های رومانوفسکی
رنگ May-Grünwald-Giemsa
این روش یک روش رنگآمیزی دو مرحلهای است که به موجب آن اولین رنگآمیزی با رنگ May-Grünwald و رنگآمیزی دوم با رنگ Giemsa انجام میشود که اثر رومانوفسکی را ایجاد میکند.
رنگ Giemsa
- این رنگ یک رنگ مخصوص برای آزمایش غشاهای خونی از نظر عفونتهای انگلی و عمدتاً برای تشخیص مالاریا است.
- همچنین از این رنگ به عنوان یک رنگ افتراقی برای سلولهای خونی مختلف (گلبولهای قرمز، پلاکتها، لکوسیتها) و اجزای سلولی مانند هسته و سیتوپلاسم استفاده میشود.
- از رنگهای اسیدی و بازی Eosin Y و متیلن بلو تشکیل شده است، از این رو یک رنگ azure است.
- رنگ Giemsa، رنگ آبی- بنفش در رنگ آمیزی هسته و رنگ قرمز-صورتی در رنگ آمیزی سیتوپلاسم و گرانولهای سیتوپلاسمی را تولید میکند.
- در سیتوژنتیک (Cytogenetics) و هیستوپاتولوژی (Histopathology) برای تشخیص موارد زیر استفاده میشود:
- مالاریا، اسپیروکتها (Spirochete) و سایر انگلهای خونی
- اجسام انکلوزیونی Chlamydia trachomatis
- Borrelia spp
- یرسینیا پستیس (Yersinia pestis)
- هیستوپلاسموزیس spp
- کیستهای پنوموسیستیس جیرووسی (Pneumocystis jiroveci)
رنگهای Wright و Wright-Giemsa
- رنگ Wright توسط James Homer Wright با اصلاح رنگ رومانوفسکی اختراع شد.
- رنگ Wright از متیلن بلو گرم شده استفاده میکند که یک polychrome methylene blue ترکیب شده با Eosin Y تولید میکند.
- به متیلن بلو گرم شده با Eosin Y اجازه داده میشود تا رسوب کند و eosinate تشکیل دهد که پس از آن با متانول حل میشود.
- این فرایند رویه رنگ Wright را مشخص میکند.
- هنگامی که رنگ Giemsa به رنگ Wright اضافه میشود، رنگ در گرانولهای سیتوپلاسمی به رنگ ارغوانی مایل به قرمز ظاهر میشود.
- این رنگ ها، رنگ های مورد استفاده در خونشناسی هستند که برای تمایز سلولهای خونی از اسمیر خون محیطی، آسپیراسیون مغز استخوان و نمونه ادرار استفاده میشوند.
- از این رنگ ها عمدتاً به عنوان رنگ های افتراقی برای انواع مختلف گلبولهای سفید استفاده میشود و همچنین میتوان از آنها برای شمارش گلبولهای سفید خون در افراد مبتلا به عفونتهای انگلی خون مانند مالاریا و اختلالاتی مانند لوسمی استفاده کرد.
- این رنگ با کشف وجود ائوزینوفیل (eosinophil) در نمونه ادرار، به تشخیص عفونت ادراری و نفریت بینابینی (Interstitial nephritis) کمک میکند.
- در سیتولوژی و سیتوژنتیک از این رنگ برای تشخیص عیوب و بیماریهای کروموزومی از طریق رنگ آمیزی کروموزومهای سلولی استفاده میشود.
- این رنگ از مخلوط eosin (قرمز) و متیلن بلو تشکیل شده است.
- ترکیبی از رنگ Wright و رنگ Giemsa به عنوان رنگ Wright-Giemsa شناخته میشود.
- رنگهایی که به Wright و Wright-Giemsa منتسب هستند، buffered Wright Stain، buffered Wright-Giemsa stain میباشند. این رنگ ها با محلول مورد استفاده برای رنگ آمیزی متمایز میشوند.
- تفاوت عمده بین رنگ Wright-Giemsa و رنگ May-Grünwald-Giemsa در شدت رنگ و مدت زمان اجرای آزمایش است.
- رنگ May-Grünwald-Giemsa زمان بیشتری برای اجرا میگیرد و پس از رنگ آمیزی، شدت رنگ زیادی ایجاد میکند.
رنگ رایت گیمسا، جهت تشخیص افتراقی دقیق ساختارهای سلولی همراه با برخی محدودیتها
رنگ Leishman
- این رنگ توسط William Leishman با استفاده از polychrome methylene blue و eosin Y و حلال متانول ساخته شده است.
- این رنگ برای ایجاد تمایز و شناسایی گلبولهای سفید، انگلهای مالاریا و تریپانوزومها (Trypanosome) استفاده میشود.
- این رنگ با استفاده از متانول به عنوان یک تثبیت کننده از سفت شدن جلوگیری میکند.
روش رنگ آمیزی Leishman:
- اسمیر خون محیطی (blood film) تازه را آماده کرده و به سرعت در هوا خشک کنید.
- روی فیلم را با Leishman’s Stain (S018S) بپوشانید و اجازه دهید 1 دقیقه عمل کند. متانول موجود در رنگ روند آمادهسازی را تثبیت میکند.
- دو برابر حجم موجود، آب مقطر به لام اضافه و مخلوط کنید.
- اجازه دهید رنگ رقیق شده به مدت 10-12 دقیقه عمل کند.
- فیلم را با آب مقطر یا بافر فسفات با pH برابر 7.0 بشویید، در هوا آبکشی و خشک کنید و نتیجه را بررسی کنید.
کاربردهای رنگ های رومانوفسکی
رنگ های رومانوفسکی در چندین مطالعه و فرایند تشخیصی، عمدتاً در تشخیص هماتولوژی و سیتولوژی، استفاده میشود. هر تکنیک رنگ آمیزی مربوط به رومانوفسکی کاربردهای خاص خود را دارد، با این حال کاربردهای کلی عبارتند از:
- رنگ های رومانوفسکی در مطالعات خونشناسی و سیتولوژی به ترتیب برای تشخیص اختلالات خونی و نقص کروموزومی استفاده میشوند.
- در آزمایش اسمیر خون محیطی برای تشخیص عفونتهای منتقله از طریق خون مانند Rickettsia و عفونتهای مرتبط با Rickettsia
- برای تشخیص نقایص مغز استخوان
مزایای رنگ های رومانوفسکی
- رنگ ها به راحتی در دسترس هستند.
- آماده سازی، نگهداری و استفاده از آنها ساده است.
معایب رنگ های رومانوفسکی
- ویژگیهای مورفولوژیکی سلول ممکن است مخدوش شود.
- استفاده از بافر با pH مورد نیاز برای اطمینان از حفظ رنگ رومانوفسکی stain مهم است.
جهت خرید و یا استعلام قیمت با ما تماس بگیرید یا در واتسپ پیام بزارید
دوره کارآموزی تکنولوژیست پاتولوژی ژنیران
مترجم: فاطمه فریادرس



